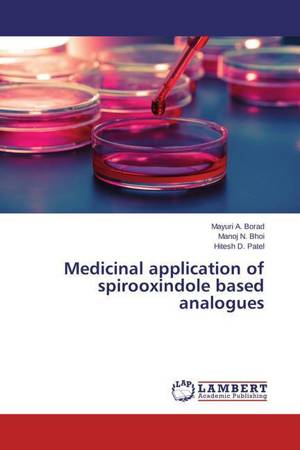

Je cadeautjes zeker op tijd in huis hebben voor de feestdagen? Kom langs in onze winkels en vind het perfecte geschenk!
- Afhalen na 1 uur in een winkel met voorraad
- Gratis thuislevering in België vanaf € 30
- Ruim aanbod met 7 miljoen producten
Je cadeautjes zeker op tijd in huis hebben voor de feestdagen? Kom langs in onze winkels en vind het perfecte geschenk!
- Afhalen na 1 uur in een winkel met voorraad
- Gratis thuislevering in België vanaf € 30
- Ruim aanbod met 7 miljoen producten
Zoeken
Resultaten voor "Hitesh D. Patel"
-
Mono, di, tri and tetra spiro heterocyclic compounds: Recent advances
Mayuri A. Borad, Manoj N. Bhoi, Hitesh D. Patel
- Paperback | Engels
- Isatins and its C-3 functionalized derivatives occupy a conspicuous place in organic synthesis and medicinal chemistry. N-substituted isatins, and isa... Lees meer
€ 35,45Levertermijn 1 à 4 weken€ 35,45Levertermijn 1 à 4 weken -
History, importance, and some basic concept of chirality
Manoj N. Bhoi, Mayuri A. Borad, Hitesh D. Patel
- Paperback | Engels
- Chiral drugs are currently 50% used and near 90% of the last ones are marketed as racemates consisting of an equimolar mixture of two enantiomers. Whi... Lees meer
€ 35,45Levertermijn 1 à 4 weken€ 35,45Levertermijn 1 à 4 weken -
Application of heterogeneous catalyst for Organic synthesis
Manoj N. Bhoi, Mayuri A. Borad, Hitesh D. Patel
- Paperback | Engels
- Increasing number of researches focusing on the use of solid heterogeneous catalysts for the synthesis of organic compound provides evidence that thes... Lees meer
€ 40,95Levertermijn 1 à 4 weken€ 40,95Levertermijn 1 à 4 weken -
A water-mediated synthesis of isatin-based aromatic compounds
Mayuri A. Borad, Manoj N. Bhoi, Hitesh D. Patel
- Paperback | Engels
- Isatin is an important scaffold in organic synthesis because of it shows various biological activities. The most attractive application of isatin in o... Lees meer
€ 38,95Levertermijn 1 à 4 weken€ 38,95Levertermijn 1 à 4 weken -
Synthesis of Benzoxazole derivatives: recent advances
Manoj N. Bhoi, Mayuri A. Borad, Hitesh D. Patel
- Paperback | Engels
- Benzoxazole is an essential building block in organic synthesis which shows various biological activities. A number of methods have been reported for ... Lees meer
€ 38,95Levertermijn 1 à 4 weken€ 38,95Levertermijn 1 à 4 weken -
Medicinal application of spirooxindole based analogues
Mayuri A. Borad, Manoj N. Bhoi, Hitesh D. Patel
- Paperback | Engels
- The chemistry and an extensive spectrum of biological activities of spirooxindole have been examined since several decades and this heterocyclic core ... Lees meer
€ 39,95Levertermijn 1 à 4 weken€ 39,95Levertermijn 1 à 4 weken -
Recent advances of 1,3,4-Oxadiazole derivative
Manoj N. Bhoi, Mayuri A. Borad, Hitesh D. Patel
- Paperback | Engels
- 1,3,4-Oxadiazole acts as a versatile framework in organic synthesis and drug development due to exhibit useful and diverse biological activities. We s... Lees meer
€ 39,95Levertermijn 1 à 4 weken€ 39,95Levertermijn 1 à 4 weken -
Recent advances of Dihydropyrimidinone derivatives
Mayuri A. Borad, Manoj N. Bhoi, Hitesh D. Patel
- Paperback | Engels
- Dihydropyrimidinone is one of the significant scaffold in synthetic organic chemistry which shows various biological aspects. Various methods have bee... Lees meer
€ 38,95Levertermijn 1 à 4 weken€ 38,95Levertermijn 1 à 4 weken -
Synthesis of imidazo[1,2-a]pyrazines derivatives: recent advances
Manoj N. Bhoi, Mayuri A. Borad, Hitesh D. Patel
- Paperback | Engels
- During the past few years, considerable attention has been focused to the development of molecular structural design and nitrogen-based heterocyclic m... Lees meer
€ 38,95Levertermijn 1 à 4 weken€ 38,95Levertermijn 1 à 4 weken -
Synthetic utility of Coumarin derivatives: recent advances
Manoj N. Bhoi, Mayuri A. Borad, Hitesh D. Patel
- Paperback | Engels
- Coumarin acts as a versatile framework in organic synthesis and drug development due to exhibit useful and diverse biological activities. We summarize... Lees meer
€ 39,95Levertermijn 1 à 4 weken€ 39,95Levertermijn 1 à 4 weken -
Sulfonic acid functionalized reusable catalysts in organic synthesis
Rajesh H. Vekariya, Hitesh D. Patel
- Paperback | Engels
- Silica gel as an accessible substrate with high surface area can be modified by propyl S-sulfonic acid. Silica-bonded S-sulfonic acid (SBSSA), silica-... Lees meer
€ 39,95Levertermijn 1 à 4 weken€ 39,95Levertermijn 1 à 4 weken -
Synthesis and Utility of Acid hydrazides
Manoj N. Bhoi, Mayuri A. Borad, Hitesh D. Patel
- Paperback | Engels
- We have focused on extreme synthetic potential of acid hydrazides for synthesis of polyfunctional heterocyclic compounds which have been reported in v... Lees meer
€ 56,95Levertermijn 1 à 4 weken€ 56,95Levertermijn 1 à 4 weken -
Synthesis of pyrrole derivatives: recent advances
Mayuri A. Borad, Manoj N. Bhoi, Hitesh D. Patel
- Paperback | Engels
- Pyrrole is an essential building block in organic synthesis. Many aromatic compounds consist of the Pyrrole moiety have stimulating applications in th... Lees meer
€ 39,95Levertermijn 1 à 4 weken€ 39,95Levertermijn 1 à 4 weken
13 van 13 resultaten getoond